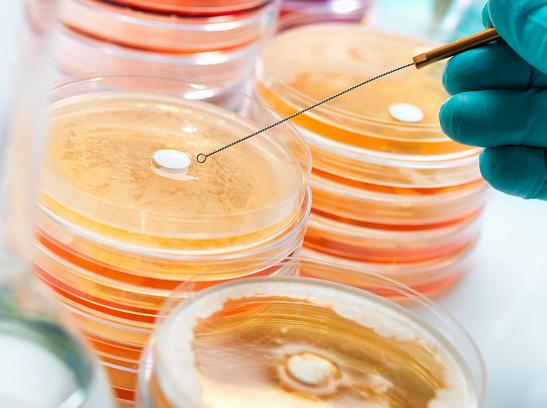

“我为群众办实事”,用心用情用力解决基层的困难事、群众的烦心事。
食品安全是民生工程、民心工程。一勺油、一碗米、一桶奶粉,看似家常小事,却也是事关千家万户 美好生活的头等大事。
一食一饭系心间,一餐一饮有监管。我们牢牢守护食品安全防线,为群众多做实事、多办好事、多解难事。敬请关注“我为群众办实事”系列报道,共同见证食安人为人民服务的初心和实践。
养殖业发展始终离不开抗菌药物
养殖户们若长期不规范使用抗生素
导致病原菌对抗菌药产生耐药性
甚至引起畜禽并发症或继发感染
增加食品安全和公共卫生风险

为了提高大家对兽药的认识
普及养殖用药和动物产品安全相关知识
中国兽药协会最新修订编制了
《兽药使用和食品安全二十五问》
干货满满、收获颇多
第一期内容给大家介绍了
关于兽药使用和兽药残留的13问
(点击上方文字链接回顾第一期内容↑)
科普如何正确使用兽药
了解兽药残留标准
今天食安君将带来第二期内容
12个关于耐药性与耐药菌
以及兽药监管、环境影响的问答

Q:
1、什么是耐药性?
A:
随着药物的使用,一些细菌逐渐适应并发展出抵抗药物作用的能力,这就是耐药性或抗药性。不仅细菌会产生耐药性,病毒、寄生虫、肿瘤细胞也会产生耐药性。

Q:
2、细菌为什么会有耐药性?
A:
耐药性是细菌对药物不敏感或敏感性下降甚至消失的特性,耐药菌是具有耐药性状的细菌。细菌对抗生素耐药是自然界中长期存在的生物现象。世界卫生组织指出,世界各地医院和养殖场是耐药菌产生的两大场所。
Q:
3、耐药菌的危害表现在哪些方面?
A:
细菌获得耐药性后,其致病性并不会增强,也不会产生新的感染类型,耐药菌最主要的危害是给治疗带来困难。如果细菌对多种抗菌药耐药,甚至对大多数抗菌药都耐药,则可导致常用抗菌药治疗无效,造成病死率提高,显著延长病程和治疗时间,大幅增加医疗成本。
Q:
4、有没有办法对付耐药菌?
A:
降低细菌耐药性产生需要多措并举,综合治理。主要措施包括:
①合理、谨慎地使用抗菌药,避免细菌耐药性产生,这是目前最有效、易推行的方法。
②研发、推广、应用抗菌药替代品。
③结合耐药性监测,采用轮换、穿梭用药,可以减少细菌耐药性甚至恢复细菌敏感性。
④针对动物源细菌耐药情况,研制新型动物专用抗菌药。
Q:
5、动物身上的耐药菌对人有无危害?
A:
虽然细菌耐药性的产生和传播规律有待研究,但目前国际上的主流观点认为:
①动物源耐药菌的产生与传播,会增加食品安全和公共卫生风险。
②由于威胁人类健康的耐药菌,甚至“超级细菌”的成因复杂,解决办法除了保证动物养殖科学规范用药外,重点应在加强人用抗生素合理使用、防止避免医院内交叉感染等方面采取有效防范措施。

Q:
6、兽药使用有哪些政府监管措施?
A:
农业农村部制定出台了一系列监管政策,发布实施了禁止使用的兽药和其他化合物目录、兽用处方药和非处方药管理办法、兽用处方药目录、兽药休药期规定等关于安全用药的政令,同时制定并实施国家兽药残留监控计划,组织开展年度兽药残留监测计划,对动物性食品中76种兽药残留进行监管检测,并对超标阳性产品实行源头追溯制度,依法进行处理。

Q:
7、养殖减抗应有哪些重要内容?
A:
养殖减抗是农业农村部近年重点工作,近年来围绕“产好药、少用药、用好药”采取了一系列监管措施,以实现养殖业抗菌药“零增长”。
主要措施:一是养殖场药要规范合理使用兽用抗菌药,建立兽药使用管理制度,严格执行兽用处方药制度和休药期制度。二是科学审慎使用兽用抗菌药,建立科学合理的用药制度,尽量科学用药、少用药。三是加强动物疫病防控管理,提高健康养殖水平,减少兽用抗菌药使用量。
Q:
8、饲料禁抗有哪些重点内容?
A:
饲料禁抗禁的是通过饲料添加、以促进动物生长为目的的抗生素类兽药产品。作为针对发病动物、用于治疗动物疾病的抗生素类兽药产品仍是允许使用的,不过必须由兽医进行临床诊断,按照规定开具处方。
根据农业农村部194号公告和第307号公告(关于养殖者自行配制饲料的有关规定)要求,商品饲料不得添加任何一种抗菌药,仅允许养殖场凭兽医处方并按照兽药标签上载明的用法和用量,采取适当的给药途径用于动物。
Q:
9、环境中为什么能检测到抗菌药?
A:
抗菌药广泛用于人类医疗、动物疾病控制和预防以及种植业和工业用途。这些药物随生产生活进入环境是难以避免的,随着检测手段越来越先进,自然环境中检出抗生素也就不奇怪了。
此外,自然环境中的很多微生物也会产生抗生素,比如青霉素就是从青霉菌的代谢物中发现的。
Q:
10、哪些环境中能检测到抗菌药?
A:
根据中国、美国、加拿大、澳大利亚、德国、意大利、西班牙、瑞典、日本等国家的数据,土壤和污泥、废水、地表水、地下水、饮用水都能检测到抗菌药成分,这种情况在各国普遍存在。但是抗菌药在环境中的浓度普遍很低,水体中的浓度一般在十亿分之一左右。

Q:
11、环境中的抗菌药成分能不能自然降解?
A:
世界卫生组织的技术报告指出,水环境中绝大多数药物的浓度均能自然降解,如吸附到沉积物上、日光降解和生物降解。饮水及废水的处理过程也会降低抗菌药的浓度。
另外在合适的堆肥条件下,畜禽粪便堆肥过程也可以有效降低抗菌药在粪便中的浓度,将对环境的影响降到最小。
Q:
12、饮水中微量的抗菌药是否会危害健康?
A:
世界卫生组织发布的《饮用水中的药物残留》技术调查报告指出:饮用水中检测出的药物浓度比最低治疗剂量低若干个数量级(通常低1000倍以上,而且往往远低于1000倍),这些极低浓度的药物残留对人体健康造成危害的可能性非常低。
比如某媒体报道,自来水中检出阿莫西林8纳克/升,以此估算,需要每天喝5吨水以上才可能有健康风险。

兽药安全无小事
正确使用是大事
普及兽药科学知识
增强养殖户的法律意识
引导养殖户按照相关法律法规
科学、合理、安全地使用兽药
是抓细抓实各项食品安全规范的重要内容
未来
执法人员加强兽药监管
严厉打击兽药违法行为
保障动物产品质量安全
势在必行

内容来源:兽药规范使用
编辑整理:深圳食药安办
转载请注明以上内容

点在看,大家看!

